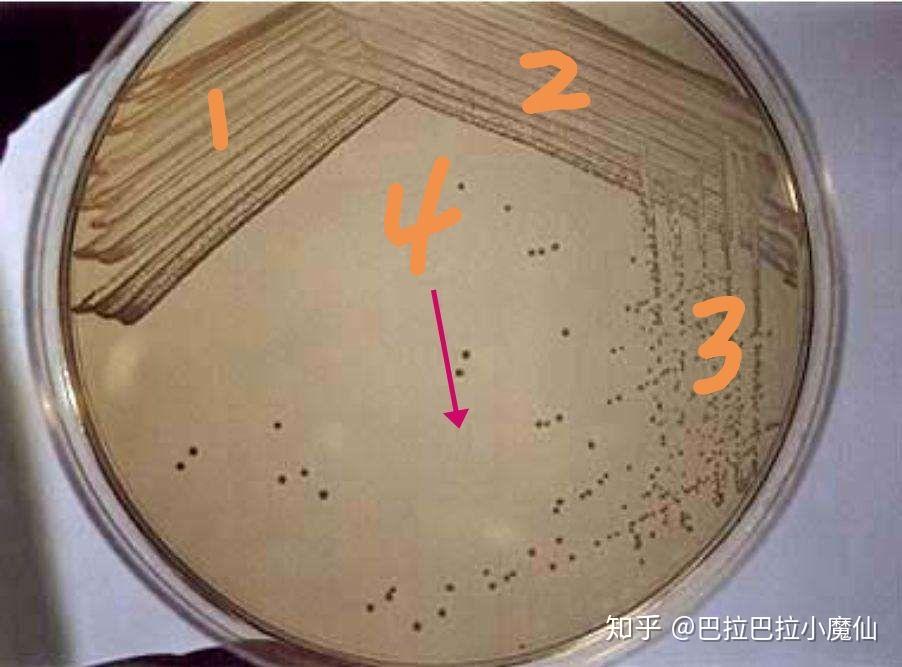
平板划线法和稀释涂布平板法到底是纯化微生物的方法还是接种方法

稀释涂布平板

稀释涂布平板法计数公式
图片尺寸793x414
高中生物实验课 | 稀释涂布平板法 | 微生物 06上周带同学们在实验
图片尺寸960x1280
上述方法称为稀释涂布平板法b.3号试管中的
图片尺寸420x200
五,稀释涂布平板法
图片尺寸947x462
而且采用稀释倒平板法也会使一些严格好氧菌因被固定在琼脂中
图片尺寸562x510
生物科学类的培养要求
图片尺寸690x517
分析:诱饵启动子重组质粒pabai-p转化y1hgold酵母菌株涂布sd/-ura平板
图片尺寸554x247
大肠杆菌稀释涂布平板法
图片尺寸828x828
五,结果分析不用二氧化氯处理的池塘水涂布平板有30多粒菌数生成,而用
图片尺寸640x480
高二生物选修一 土壤中分解尿素的细菌的分离与计数(63张ppt人教版)
图片尺寸720x405
系列稀释操作【纯化分离的方法二-稀释涂布平板法】【纯化分离的方法
图片尺寸640x285
涂布平板法(spread platemethod)
图片尺寸565x223
平板划线法为什么不能计数,稀释涂布平板法为什么可以计数和纯化.
图片尺寸534x300
稀释涂布(平板)法
图片尺寸686x420
平板划线法和稀释涂布平板法到底是纯化微生物的方法还是接种方法
图片尺寸902x667
大肠杆菌稀释涂布平板法
图片尺寸828x828
用稀释涂布平板法统计样品中细菌的数目时,为了提高实验结果的可信度
图片尺寸572x236
高二生物选修一 土壤中分解尿素的细菌的分离与计数(63张ppt人教版)
图片尺寸720x405
缺点:接种前需梯度稀释,吸收量较少,较麻烦,平板不干燥效果不好,容易
图片尺寸532x345
haoda 梯度稀释平板分离法: 梯度稀释平板分离法:倾注平板法和涂布平
图片尺寸1080x810